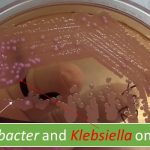
Hospital acquired infection

Tag: hospital acquired infection
Biomedical Waste: Introduction, Its Management Objectives and Source
 Biomedical waste Outlines of the topic contain an introduction, aims...
Biomedical waste Outlines of the topic contain an introduction, aims...
Hospital acquired infection: Introduction, common pathogens, types of infections, transmission, prevention and treatment
Hospital acquired infection: Introduction, common pathogens, types of infections, transmission,...
Hospital acquired infection: Introduction, common pathogens, types of infections, transmission,...
Microbiology color atlas: Introduction, Picture Collections and Their Description
 Introduction of Microbiology Color Atlas The name ' Microbiology color atlas'...
Introduction of Microbiology Color Atlas The name ' Microbiology color atlas'...
